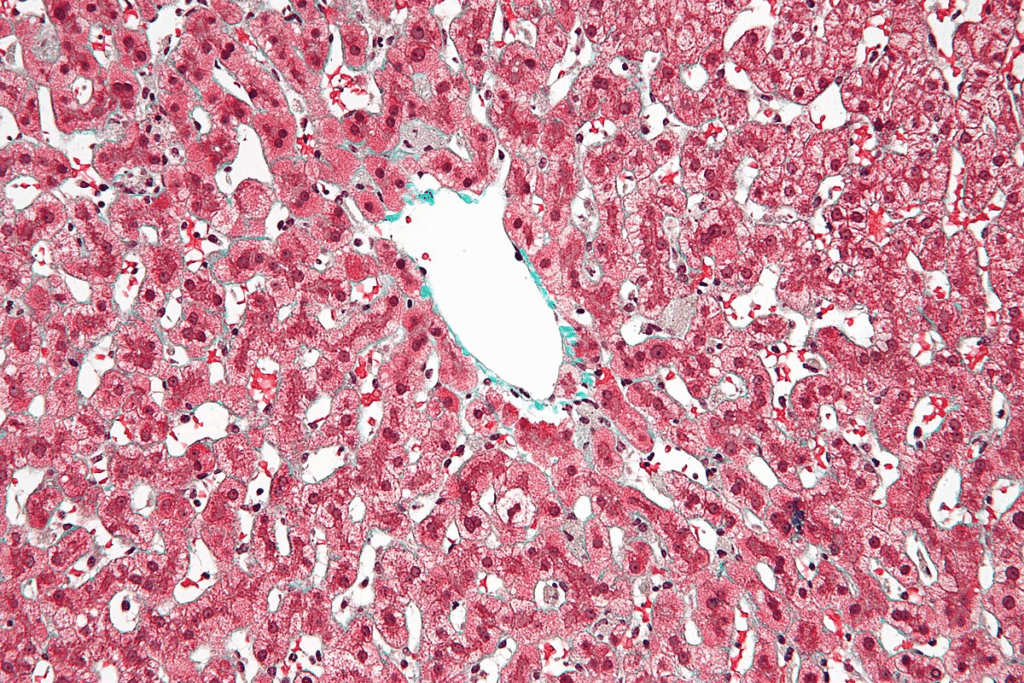
Liver Regeneration After Removal: Amazing Facts on This Powerful Organ

Did you know the human body can regrow some organs? The liver is a great example. It can grow back to its original size even if a big part is taken out. This ability to regenerate is key for getting better after liver surgery. How fast is Liver regeneration after removal? Discover the amazing facts on this powerful organ’s unique ability to grow back.
We’re learning more about how the liver can heal itself. This is very important for people having liver surgery. The liver can grow back because of special cells called hepatic cells. These cells can multiply and fix damaged areas, helping with liver surgery recovery and health.
This amazing skill is backed by many medical studies. They show the liver’s special ability to regenerate hepatic tissue. Knowing about this can help us understand how well someone can recover and what affects it.
Key Takeaways
- The liver has a unique capacity to regenerate itself after injury or surgery.
- Liver regeneration is crucial for recovery after liver removal or surgery.
- Hepatic cells play a significant role in the liver’s ability to regrow.
- Understanding liver regeneration can provide insights into recovery potential.
- Various medical studies support the liver’s capacity for regeneration.
The Remarkable Regenerative Capacity of the Human Liver
The liver can regrow itself in a way no other organ can. This amazing ability has caught the eye of doctors for centuries. We’ll dive into the history of liver regrowth and why it’s so special.
Historical Understanding of Liver Regeneration
Long ago, even the ancient Greeks knew the liver could heal itself. They told stories like the one of Prometheus, whose liver was eaten by an eagle every day. Yet, it grew back every night. This myth shows how long people have been amazed by the liver’s power.
In the 20th century, scientists really started to understand how the liver regenerates. They found out it can grow back a lot after being cut down. This has been seen in many studies.
The Liver’s Unique Position Among Human Organs
The liver is special because it can grow back even after a big part is removed. This is important for healing after liver surgery or damage. It’s a key reason why the liver is so fascinating.
To see why the liver is so special, let’s compare it with other organs. Here’s a table that shows its unique role:
| Organ | Regenerative Capacity | Regrowth After Surgery |
| Liver | High | Significant regrowth |
| Kidney | Moderate | Limited regrowth |
| Heart | Low | Minimal regrowth |
The table shows the liver can regrow much more than other important organs. This makes it a key area for medical research. It’s especially interesting for learning about liver regeneration mechanisms and enhancing liver regeneration.
We’ll keep looking into how the liver regenerates. We’ll explore the biological processes and what affects it in the next parts.
Understanding Liver Anatomy and Function

To understand how the liver regenerates, we must first know its structure and functions. The liver is a vital organ with a complex structure. It plays many roles in our body.
Basic Structure of the Liver
The liver sits in the upper right of the belly. It has four lobes: right, left, caudate, and quadrate. Hepatocytes, the main liver cells, handle detoxification and metabolism.
Liver lobules are its working parts. They have hepatocytes around a central vein. The liver gets blood from the hepatic artery and portal vein. This setup helps it filter toxins and make digestive enzymes.
Essential Functions the Liver Performs
The liver does many important things. It:
- Detoxifies the blood by removing harmful substances.
- Makes proteins for blood clotting and nutrient transport.
- Creates digestive enzymes like bile.
- Metabolizes fats, proteins, and carbs.
- Stores glycogen, vitamins, and minerals.
These roles show why the liver is key to our health. It can also grow back after damage. This is thanks to its regenerative capacity and hepatic tissue regeneration abilities.
In short, the liver’s structure and functions are closely tied. Its ability to regenerate shows its importance and complexity.
Liver Regeneration After Removal: The Biological Process
When a part of the liver is taken out, the body starts a remarkable healing process. This is key for patients who have liver surgery, like those with liver cancer or donors for liver transplants.
Cellular Mechanisms of Regeneration
The liver’s ability to heal comes from its special cells and how they work together. Hepatocytes, the liver’s main cells, are vital in this healing process.
The healing starts with hepatocytes getting active and growing to replace the lost liver. This growth is guided by a network of signals that help cells work together.
Growth Factors and Signaling Pathways
Hepatocyte growth factor (HGF) and epidermal growth factor (EGF) are important for growing more hepatocytes. The Wnt/β-catenin pathway also helps by controlling genes needed for liver healing.
The Role of Hepatocytes in Regeneration
Hepatocytes are the liver’s main workers. They grow fast to fix the liver’s size and function when it’s damaged. Their ability to grow back is what makes the liver heal from injuries or surgery.
| Factor | Role in Regeneration |
| Hepatocyte Growth Factor (HGF) | Promotes hepatocyte proliferation |
| Epidermal Growth Factor (EGF) | Stimulates cell growth and differentiation |
| Wnt/β-catenin Pathway | Regulates gene expression for regeneration |
In summary, the liver’s healing after removal is a complex process. It involves many cell types, growth factors, and signals working together. Knowing how this works is key to helping the liver heal better and improving patient care.
Types of Liver Surgeries and Their Impact on Regeneratio
It’s important to know about liver surgeries and how they affect liver regeneration. Liver surgery is done for many reasons, like liver cancer or cirrhosis. The liver’s ability to heal can change based on the surgery type.
Partial Hepatectomy
Partial hepatectomy means removing part of the liver. It’s often done to take out tumors or damaged liver. The liver can grow back, and it might even get back to normal size and work.
The healing process depends on how much liver is removed and the patient’s health.
Liver Transplantation
Liver transplantation replaces a sick liver with a healthy one from a donor. This surgery greatly affects liver healing, as the new liver starts working and might grow back. The success of the transplant depends on the patient’s health and the donor liver quality.
Tumor Resections
Tumor resections remove liver tumors while keeping healthy liver tissue. The aim is to get rid of the cancer while keeping enough liver function. How well the liver heals after this surgery is key to the patient’s recovery and survival.
In summary, the type of liver surgery greatly affects liver regeneration. Knowing these differences helps manage patient hopes and improve care after surgery. Healthcare providers can support liver healing and recovery by considering the surgery type and patient factors.
How Much Liver Can Be Safely Removed?
It’s important to know how much liver can be safely removed for good results. The liver can grow back, but there’s a limit to how much can be taken out. This is important for recovery.
The “Critical Mass” Concept
The “critical mass” idea is about the minimum liver needed for it to work right and grow back. Studies show the liver can heal even after a big part is removed. But, there’s a point where it can’t heal properly.
Key Factors Influencing Critical Mass:
- The overall health of the patient
- The presence of underlying liver disease
- The surgical technique used
A top liver doctor says, “The critical mass isn’t just about how much liver is taken out. It’s also about the quality of what’s left. The liver’s ability to regenerate is influenced by various factors, including the patient’s age, nutritional status, and the presence of any underlying liver conditions.
Variations Based on Individual Health Factors
How much liver can be safely removed changes a lot based on health. For example, someone healthy can usually handle more liver removal than someone with liver problems.
| Health Factor | Impact on Liver Regeneration |
| Age | Younger patients tend to have better regenerative capacity |
| Nutritional Status | Adequate nutrition supports liver regeneration |
| Underlying Liver Disease | Presence of disease can impair regeneration |
Pre-Surgical Volume Assessment
Before surgery, doctors need to figure out how much liver will be left. They use scans to guess this. This helps them know how much liver they can safely remove.
By looking at these factors and using scans, doctors can make sure the surgery goes well. This helps the liver heal naturally.
The Timeline of Liver Regeneration After Removal
Liver regeneration after surgery has a clear timeline with different stages. Each stage is crucial for the liver’s recovery. We’ll explore the main phases of liver regeneration, shedding light on the biological processes involved.
Initial Regenerative Response (First 24-48 Hours)
The first phase of liver regeneration starts right after surgery. It involves complex cellular signals.
In the first 24-48 hours, the body starts a series of events for regeneration. Growth factors and cytokines are released. These are key for the next stages of regeneration.
Rapid Growth Phase (First Two Weeks)
The liver then enters a rapid growth phase, usually within two weeks after surgery.
Hepatocytes, the liver’s main cells, start growing fast. This growth is supported by growth factors and signaling pathways. They help new cells fit into the liver’s structure.
Complete Functional Recovery (1-3 Months)
The final stage is when the liver fully recovers, taking 1-3 months.
In this phase, the new liver tissue matures and works as it should. The liver regains its metabolic and detox functions. This marks the end of the regeneration process.
In conclusion, liver regeneration after removal is a detailed, multi-stage process. It’s both intriguing and vital for patient recovery. Knowing this timeline helps manage expectations and improve post-surgical care.
| Phase | Timeline | Description |
| Initial Regenerative Response | First 24-48 Hours | Immediate response to liver removal, involving cellular signaling pathways. |
| Rapid Growth Phase | First Two Weeks | Rapid proliferation of hepatocytes, supported by growth factors. |
| Complete Functional Recovery | 1-3 Months | Maturation of new liver tissue and resumption of normal liver functions. |
Factors That Enhance Liver Regeneration After Removal
The liver can heal itself after surgery. This healing process is helped by different factors. Knowing what helps the liver heal is key to better recovery.
Nutritional Considerations
Eating right is important for liver healing. A diet full of nutrients helps the liver repair itself. Protein is especially important for fixing tissues.
Foods like fruits and veggies are good for the liver. They help fight off damage. Vitamin E and omega-3 fatty acids are also good for the liver. They help reduce damage and inflammation.
Lifestyle Modifications
Changing your lifestyle can also help the liver heal. Staying at a healthy weight and exercising regularly are good for the liver. Drinking too much alcohol is bad for the liver.
Quitting smoking is also important. Smoking harms the liver and makes it harder to heal. Stopping smoking can greatly improve liver health.
Medical Interventions
Some medical treatments can help the liver heal. Growth factor therapy and other treatments aim to boost healing. They help the liver repair itself faster.
Good care after surgery is also key. Doctors can help with medications and treatments. This helps the liver heal better and faster.
Factors That May Impair Liver Regeneration
The liver can heal itself, but some things can slow it down. Liver repair after damage or surgery is complex. It can be affected by health issues, age, and certain drugs or toxins.
Pre-existing Liver Conditions
Having a pre-existing liver condition can really affect its healing. Diseases like cirrhosis, fatty liver, and chronic hepatitis can make it harder for the liver to heal. Cirrhosis, in particular, can severely limit the liver’s regenerative capacity due to the extensive scarring and fibrosis that characterizes this condition.
| Pre-existing Condition | Impact on Regeneration |
| Cirrhosis | Severe impairment due to scarring and fibrosis |
| Fatty Liver Disease | Moderate impairment due to inflammation and fat accumulation |
| Chronic Hepatitis | Variable impairment depending on the severity of inflammation |
Age and Regenerative Capacity
Age also plays a big role in liver healing. Older people tend to heal slower than younger ones. This is because older cells grow less and face more damage.
Medications and Substances That Affect Regeneration
Some drugs and substances can hurt liver healing. For example, chemotherapy, some antibiotics, and too much alcohol can be harmful. It’s important for patients to tell their doctors about any drugs or substances they use to check for risks to liver healing.
Knowing about these factors helps in better care after surgery. By dealing with these risks, doctors can help patients heal faster and keep their liver healthy.
Living Donor Liver Transplantation and Regeneration
In living donor liver transplantation, the liver’s ability to grow back is key for both the donor and the recipient. This complex surgery takes a part of a healthy liver from a donor and puts it in someone who needs it.
Regeneration in Donors
Donors go through a remarkable healing process after giving a part of their liver. The liver can grow back to its full size, regaining its full function. Studies show that in a few weeks, the donor’s liver can almost get back to its original size. But, how fast it grows back can vary from person to person.
Factors that affect how fast a donor’s liver grows back include their health, age, and how much liver was taken. Younger donors and those in better health tend to heal faster and more completely.
Regeneration in Recipients
Recipients also see their liver grow back after a transplant. The liver starts working better soon after surgery. Most people get back to normal in a few months.
The ability of the transplanted liver to grow back depends on several things. These include the quality of the liver donated, the recipient’s health, and any conditions that might affect the liver.
Long-term Outcomes
Most people do well in the long run after a living donor liver transplant. They can usually get back to their usual activities in a few months. But, both donors and recipients need to be closely watched to make sure their liver is working right and to catch any problems early.
| Aspect | Donors | Recipients |
| Regeneration Timeline | Several weeks to months | Several months |
| Influencing Factors | Age, health, proportion of liver removed | Liver quality, overall health, underlying conditions |
| Long-term Outcome | Generally positive, return to normal activities | Generally positive, improved liver function |
Understanding how the liver regenerates in donors and recipients helps doctors take better care of them. This improves the chances of success for living donor liver transplants.
Post-Surgical Care to Support Liver Regeneration
After surgery, supporting liver regeneration is key. Good care helps the liver heal faster and avoids problems. We’ll talk about the important steps in post-surgical care for liver regeneration.
Immediate Post-Operative Care
The first days after liver surgery are very important. Close monitoring in an ICU or liver care unit helps manage early issues. We focus on:
- Watching liver function tests to see how the liver is doing
- Managing pain well to lessen body stress
- Using antibiotics to prevent infections
Medication Management
Managing medications is a big part of care after surgery. We pick medicines that help the liver and avoid harmful ones. Changing medication plans after surgery helps the liver heal better.
Important things to think about include:
- Choosing medicines that are safe for the liver
- Staying away from drugs that can hurt the liver
- Changing doses based on how the liver is doing
Physical Activity Guidelines
Physical activity is important in recovery after liver surgery. Rest is needed first, but gradual mobilization and exercise help a lot. We suggest:
- Starting with light movements and short walks
- Slowly making physical activity more intense and longer
- Staying away from heavy lifting and hard activities
By following these tips, patients can help their liver heal and get better faster.
Monitoring Liver Regeneration After Surgery
It’s key to watch how the liver recovers after surgery. After a liver surgery, like a partial hepatectomy or transplant, the liver starts to grow back. We use different ways to check this growth, making sure the liver works well and the patient heals right.
Imaging Techniques
Imaging is a big help in watching liver growth. We look at the liver’s size, shape, and how it works. Some common imaging tools are:
- Ultrasound: A non-invasive way to see the liver’s shape and spot problems.
- Computed Tomography (CT) Scan: Gives detailed pictures of the liver, helping us see its size and any issues.
- Magnetic Resonance Imaging (MRI): Gives clear pictures of the liver, helping us check its structure and function.
Laboratory Tests and Biomarkers
We also use lab tests and biomarkers to check liver growth. These tests help us see how the liver is doing and spot any problems. Some important tests are:
| Laboratory Test | Purpose |
| Liver Function Tests (LFTs) | Check liver health by looking at enzymes and proteins. |
| Albumin Levels | See how well the liver makes proteins. |
| Bilirubin Levels | Check if the liver can handle bilirubin. |
Clinical Assessment Methods
Checking the patient’s overall health is also important. We look for signs of liver trouble or failure. This includes checking symptoms, doing physical exams, and looking at lab and imaging results.
By using all these methods, we can keep a close eye on liver growth after surgery. This helps make sure patients get the best care and support as they recover.
Potential Complications During the Regeneration Process
It’s important for patients with liver surgery to know about possible complications. The liver can heal itself, but there are risks involved.
Liver Failure Risk
Liver failure is a big risk. It happens when the liver can’t heal enough to keep the body working. This risk depends on the liver’s health before surgery, how much liver is removed, and the patient’s overall health.
Liver failure can show up in different ways, including:
- Jaundice
- Coagulopathy
- Encephalopathy
- Hepatorenal syndrome
Infection and Inflammation
Infection and inflammation are also risks. They can come from surgery problems, care issues, or a weak immune system.
It’s key to control infections. This can involve:
- Prophylactic antibiotics
- Strict wound care
- Watching for signs of infection
| Complication | Description | Risk Factors |
| Liver Failure | Inability of the liver to regenerate and support bodily functions | Pre-existing liver disease, extent of liver removal |
| Infection | Postoperative infection due to surgical or care-related issues | Compromised immune status, surgical complications |
| Abnormal Regeneration | Irregular liver regeneration patterns | Genetic factors, underlying health conditions |
Abnormal Regeneration Patterns
Abnormal liver healing can happen too. This is due to genetics or health issues.
The liver’s regenerative capacity is influenced by a complex interplay of cellular and molecular mechanisms. Understanding these mechanisms is key to mitigating potential complications. The liver’s healing after surgery is complex and can lead to complications. Knowing these risks and how to manage them is vital for better patient care.
Latest Research and Advancements in Liver Regeneration
The field of liver regeneration is moving fast, thanks to new research and tech. We’re entering a new era in treating liver conditions. This is all thanks to progress in many medical areas.
Stem Cell Therapies
Stem cell therapies are showing great promise for enhancing liver regeneration. Researchers are using stem cells to repair or replace damaged liver tissue. They’ve found that stem cells can turn into liver cells, helping the liver heal.
A recent study in a top medical journal showed stem cell therapy’s success. It helped patients with liver failure see big improvements in their liver function.
Bioengineered Liver Tissues
Creating bioengineered liver tissues is another big step forward. This method makes real liver tissue using biomaterials and cell cultures. It could help those with severe liver damage.
Scientists are working on regenerating liver function with these tissues. They use special scaffolds that help liver cells grow. These scaffolds are made to act like the liver’s natural environment.
Pharmacological Enhancements
Pharmacological enhancements are also a key area of research in liver regeneration after removal. Researchers are looking at drugs and compounds to help the liver heal. These could make liver surgery outcomes better.
| Research Area | Description | Potential Benefits |
| Stem Cell Therapies | Utilizing stem cells to repair or replace damaged liver tissue | Enhanced liver regeneration, improved liver function |
| Bioengineered Liver Tissues | Creating functional liver tissue using biomaterials and cell cultures | Restoration of liver function, potential for transplantation |
| Pharmacological Enhancements | Using drugs to stimulate liver regeneration | Improved outcomes for liver surgery patients, enhanced regeneration |
As research keeps moving forward, we’ll see big changes in liver regeneration. These new ideas are very promising for patients with liver issues or those having liver surgery.
Patient Experiences: Recovery After Liver Surgery
Recovering from liver surgery is different for everyone. It depends on the surgery type, health, and following care instructions. Knowing what to expect can help ease worries for those having liver surgery.
Physical Recovery Timeline
The time it takes to recover physically can vary. But, most people see improvement over weeks to months. First, managing pain is key, and this usually gets better in a few weeks. Eating well is also important for liver healing and health.
In the first weeks, avoid heavy lifting and hard work. Slowly, you can start doing normal things again, as your doctor advises. The liver heals fast, and most see big improvements in 1-3 months.
Psychological Aspects of Recovery
Recovering mentally is just as vital as physically. Patients might feel many emotions, like anxiety or relief, after surgery. Having support from loved ones and doctors is key to dealing with these feelings.
It’s good to stay in touch with your support group and get help if you’re feeling down or anxious for too long. Keeping a positive mindset and seeing your progress can greatly improve your mood.
Return to Normal Activities
Getting back to normal after liver surgery takes time. Always follow your doctor’s advice on when to start doing things again. Most people can get back to most activities in 2-3 months, but it can differ.
Listen to your body and don’t rush back too fast. Start slowly with regular activities to ensure a safe recovery. Regular check-ups with your healthcare team are also important to track your progress and address any issues.
Conclusion: The Liver’s Extraordinary Ability to Regenerate
The liver can grow back after it’s removed, thanks to a complex process. This process is influenced by many factors, like the liver’s own mechanism and a person’s health. Knowing these factors is key to helping the liver heal better and improving patient results.
In this article, we’ve looked at how the liver can regrow itself. We’ve talked about the biological steps involved, the effects of different liver surgeries, and what can help or hinder healing. Understanding these details helps doctors care for patients better during liver surgery.
As scientists learn more about liver regeneration, new ways to boost this process are being found. By combining medical knowledge with a deeper understanding of the liver’s healing powers, we can offer better treatments and results for patients needing liver surgery.
FAQ
What is liver regeneration, and why is it important?
Liver regeneration is when the liver grows back after injury or part removal. It’s key for fixing liver function and health after surgery or damage.
How much of the liver can be removed before it stops regenerating?
The safe removal amount depends on health and liver disease. Usually, up to 70-80% can be removed. But, a pre-surgery check is needed to ensure enough liver stays.
What factors enhance liver regeneration after removal?
Good nutrition, lifestyle changes, and medical help can boost liver growth. Eating right, avoiding harmful substances, and managing health issues are important.
How long does it take for the liver to regenerate after surgery?
Liver growth times vary. The first 24-48 hours see a quick start. Then, a fast growth phase follows for two weeks. Full recovery might take 1-3 months.
What are the potential complications during the liver regeneration process?
Risks include liver failure, infection, and abnormal growth. Close monitoring and care after surgery help avoid these issues.
Can pre-existing liver conditions affect liver regeneration?
Yes, conditions like cirrhosis or fatty liver disease can slow regeneration. The impact depends on the condition’s severity.
How is liver regeneration monitored after surgery?
Monitoring uses CT or MRI scans, lab tests, and clinical checks. These help track recovery and spot complications.
What role do hepatocytes play in liver regeneration?
Hepatocytes are key for liver growth. They can multiply to replace lost liver tissue and restore function.
Are there any new advancements in enhancing liver regeneration?
Yes, research focuses on stem cell therapies, bioengineered livers, and drugs to boost regeneration.
How does age affect liver regeneration?
Older people might regenerate slower. But, health also plays a big role, and results vary.
What lifestyle changes can support liver regeneration?
Eating well, avoiding harmful substances, managing stress, and staying active help liver health and growth.
Can medications affect liver regeneration?
Some drugs can slow liver growth. Always talk to a doctor about medications and their effects on the liver.
References:
- Hora, S. (2023). Liver Injury and Regeneration: Current Understanding, New Perspectives. Frontiers in Medicine. https://pmc.ncbi.nlm.nih.gov/articles/PMC10486351